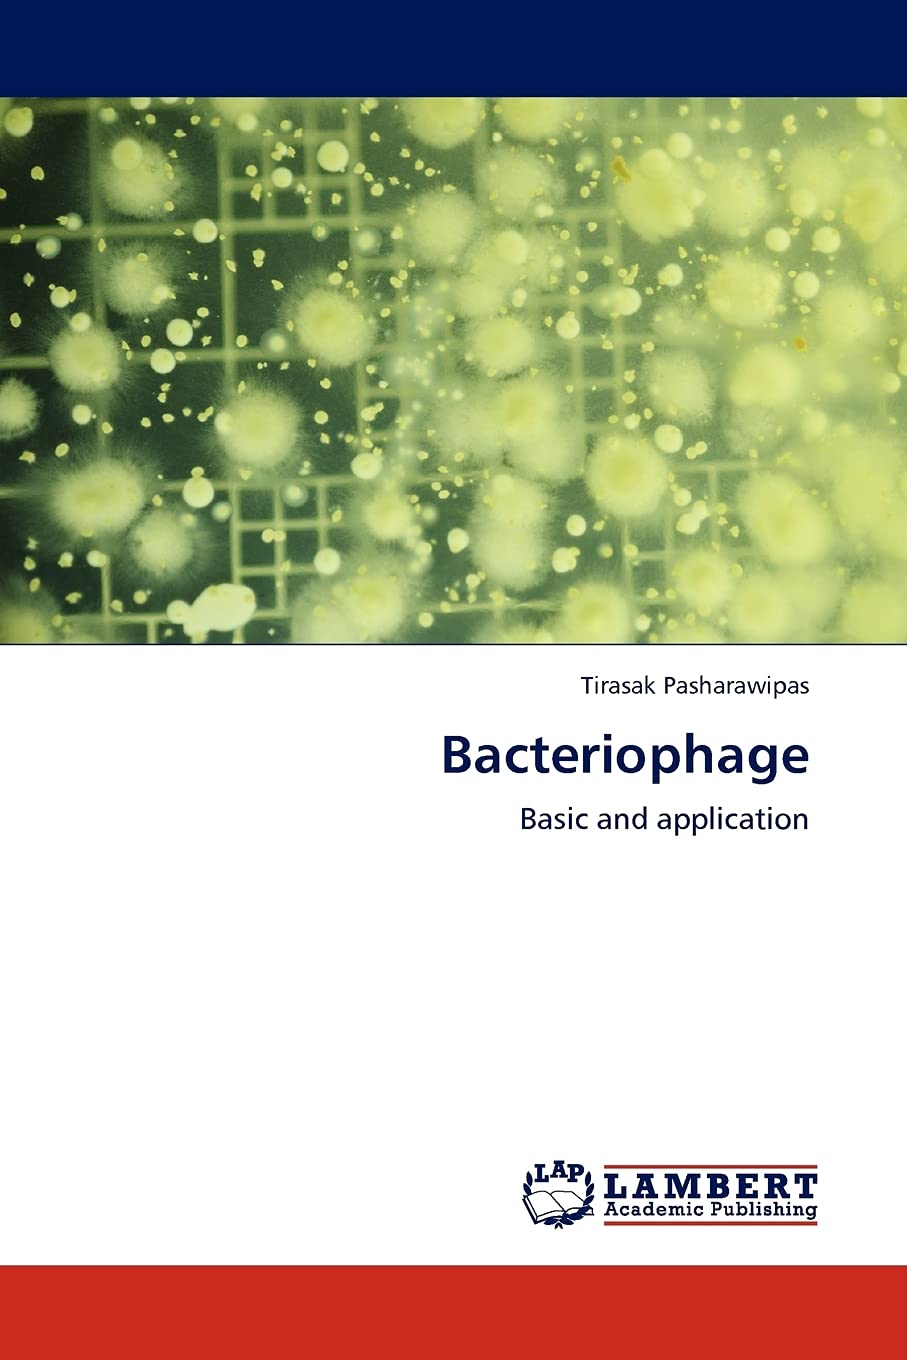
Bacteriophage: Basic and application

Buy Bacteriophage: Basic and application on desertcart.com ✓ FREE SHIPPING on qualified orders
| Dimensions | 5.91 x 0.21 x 8.66 inches |
| ISBN-10 | 3844397396 |
| ISBN-13 | 978-3844397390 |
| Item Weight | 5.1 ounces |
| Language | English |
| Print length | 92 pages |
| Publication date | July 16, 2011 |
| Publisher | LAP LAMBERT Academic Publishing |
Trustpilot
Hace 2 meses
Hace 3 días
Hace 4 días
Hace 2 semanas